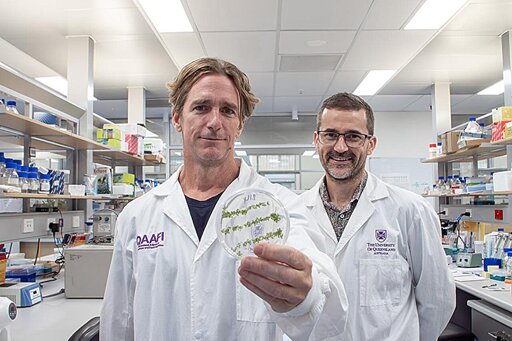

University of Queensland research has revealed that double-stranded RNA-based biopesticides (dsRNA) sprayed on plant leaves can travel right down into root systems. Led by Dr. Chris Brosnan at UQ’s Queensland Alliance for Agriculture and Food Science, the work also disproves a long-standing misconception that dsRNA directly enters plant cells. The research is published in Nucleic Acids Research.
From Biology News - Evolution, Cell theory, Gene theory, Microbiology, Biotechnology via This RSS Feed.
You must log in or # to comment.